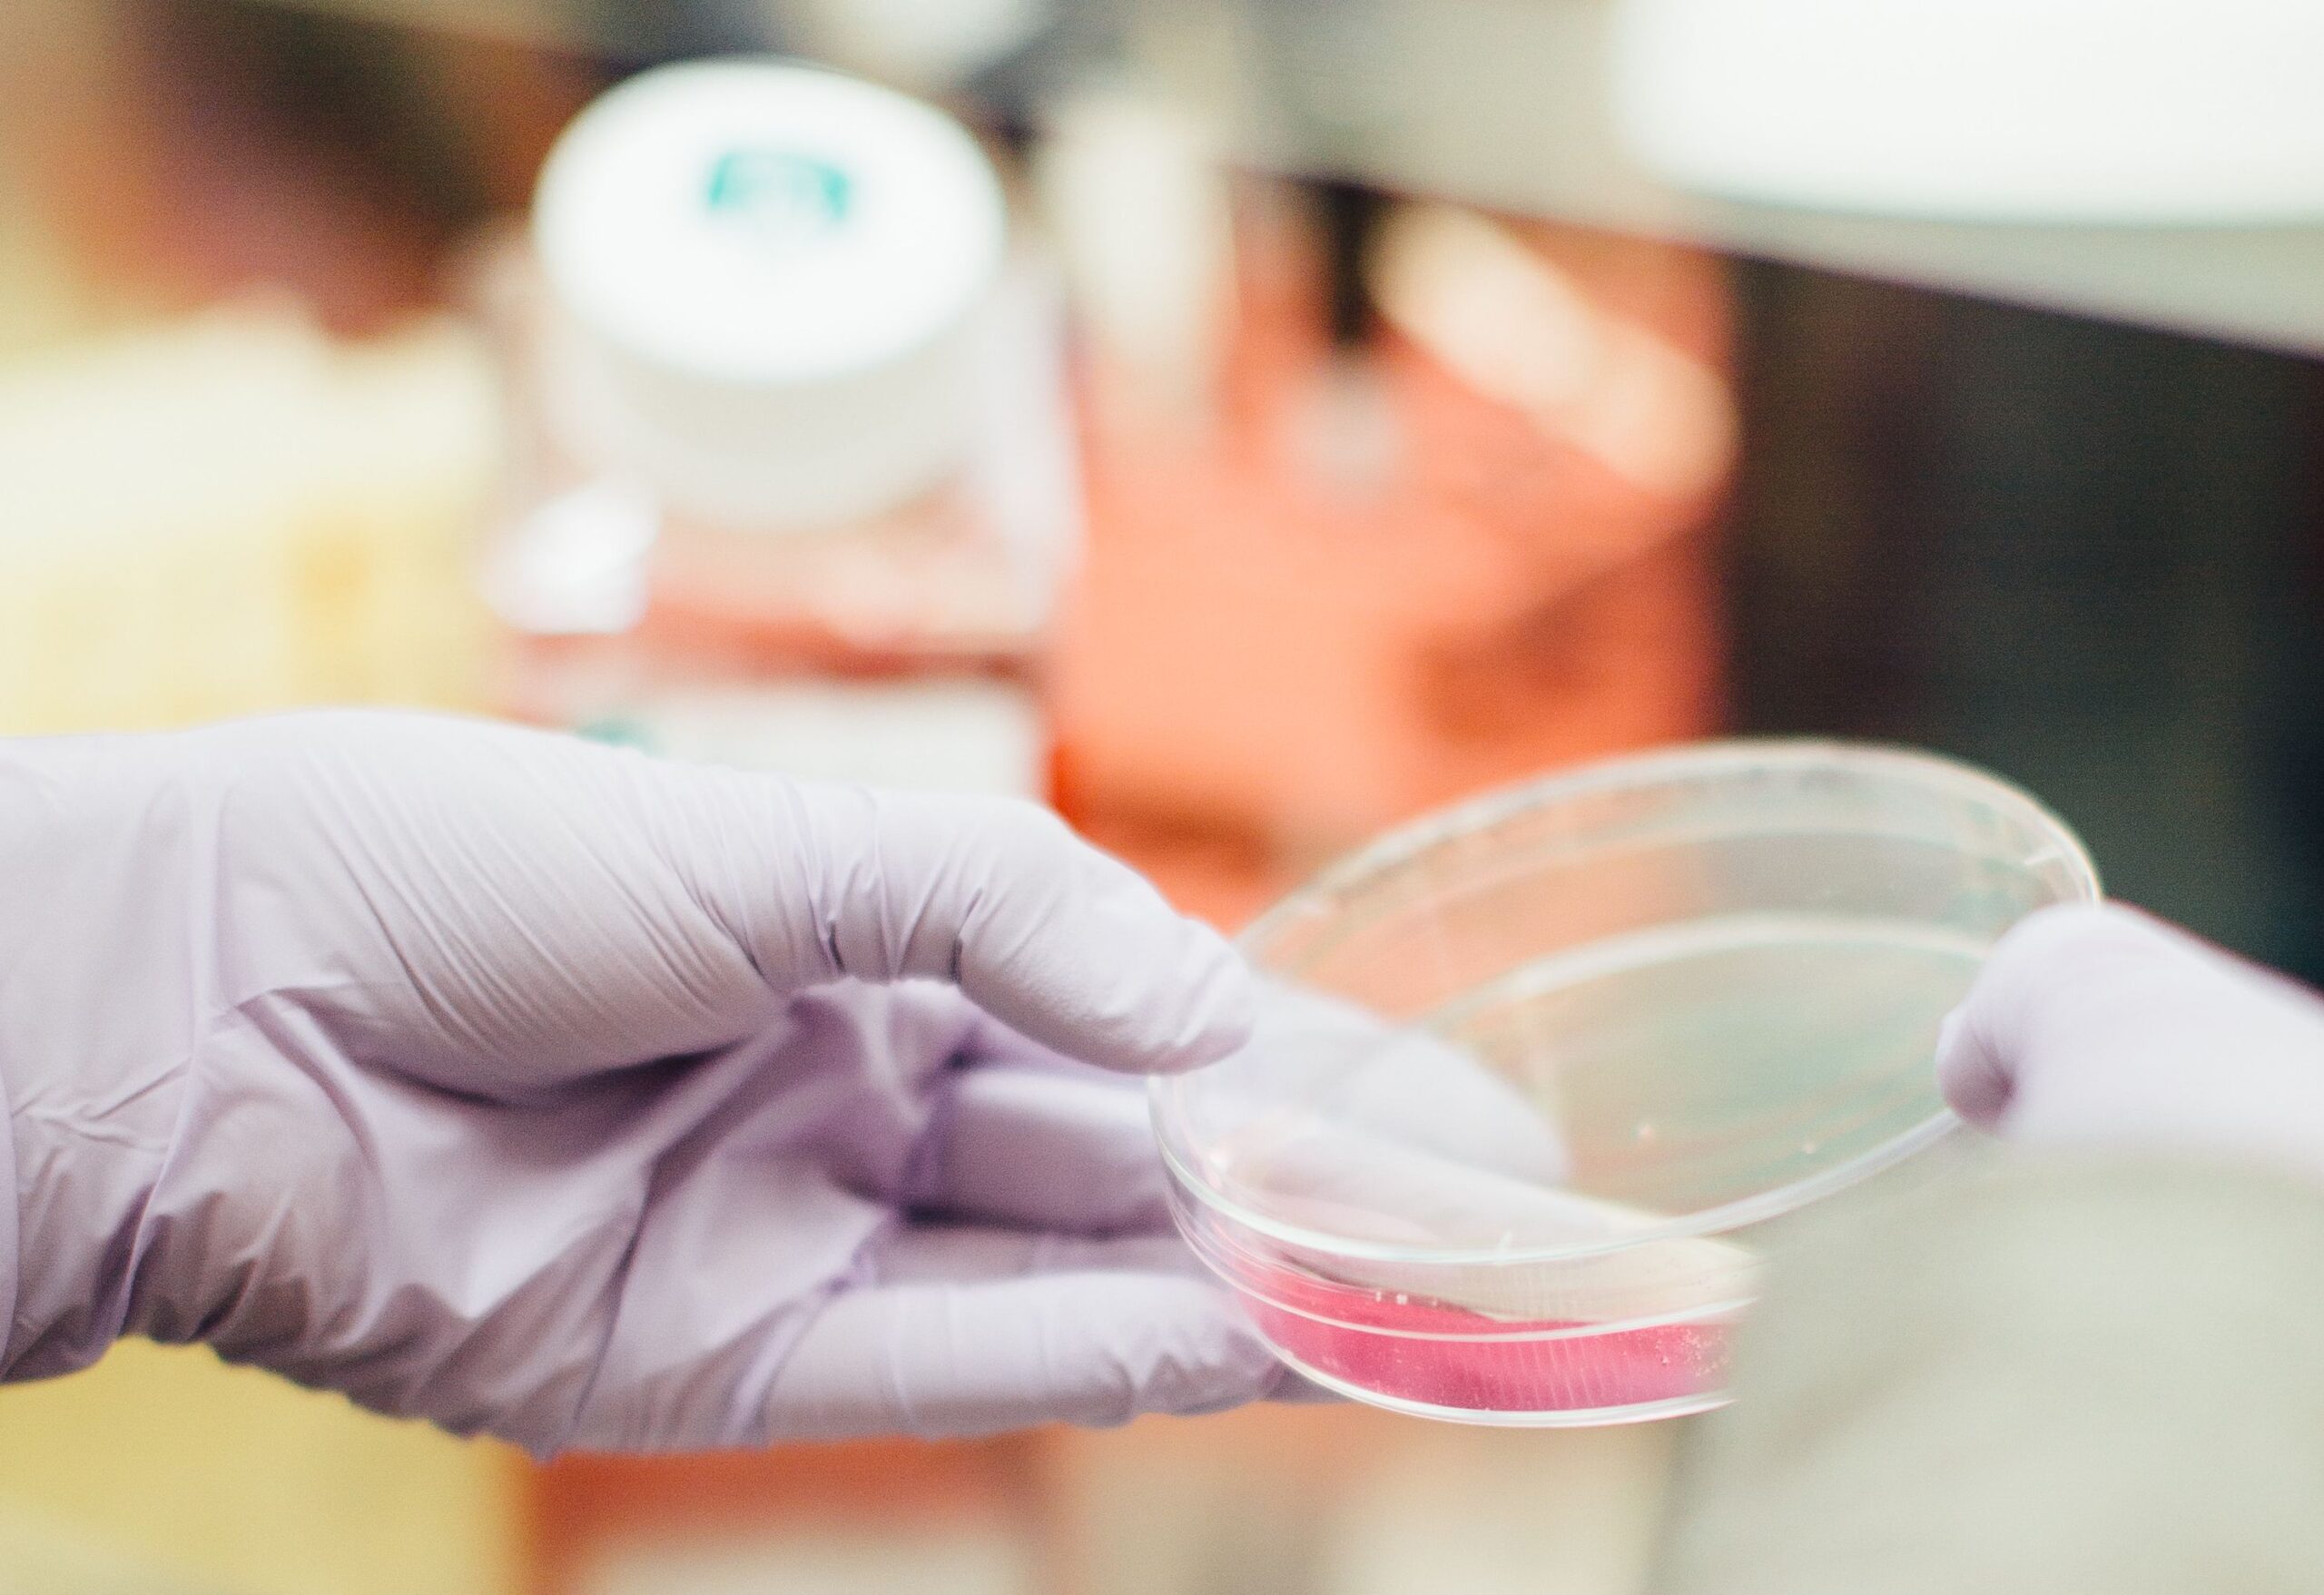
cell culture with hand and round conatiner 1

鄧守成醫師
**花蓮慈濟醫院細胞治療中心主任,美國哈佛醫學院臨床研究員**
鄧守成醫師,作為花蓮慈濟醫院細胞治療中心的領導者,擁有卓越的醫學背景和廣泛的國際經驗。他在美國哈佛醫學院深造,積累了豐富的醫療知識和技能,使他能夠在細胞治療領域不斷推動科學的前沿。
**曾隨臺灣前領導人馬英九先生出訪的醫師**
曾作為馬英九先生的隨行醫師,為國家元首提供醫療保健支援。這個經驗使他能夠理解和處理不同文化和醫療體系的複雜性。
**多重醫學協會的活躍成員**
鄧醫師是多個醫學協會的活躍成員,包括中華美容醫學會、海峽兩岸中國整形協會和國際整形重建與美容外科學會等。他還是抗衰老再生醫學領域的專家,深受國際醫學界的尊敬。
**在全球演講和教育方面的專業知識**
鄧醫師曾在國際醫學會議上發表演講,包括第二屆南京醫學抗衰老暨脂肪幹細胞研究與應用學術大會、第六屆中國微創醫學大會和第五屆世界傷口照護學會義大利國際演說等。他積極分享他的醫學知識和研究成果。
**人道工作**
鄧醫師也是一名熱心的人道工作者,在尼泊爾、不丹和印度等地進行義診醫療服務,為需要幫助的社區提供醫療支援。他的使命不僅在於改善個體的健康,還在於改善整個社會的福祉。
鄧守成醫師將他的專業知識和醫療技能獻給了醫學領域,同時也深受國際社區的尊敬。他不僅是一名傑出的醫師,也為患者提供了信仰和希望,還是一位關心社會和人類健康的宣導者。
鄧守成醫師的專精領域
鄧醫師的專業知識覆蓋廣泛,他的專精領域包括:
– **幹細胞用於皮下及軟組織填充:** 他在此領域有著深入的研究和實踐,為患者提供美容和整形方面的先進治療。
– **脂肪移植與脂肪幹細胞研究:** 他的研究對於脂肪移植和幹細胞的應用在醫療美容和再生醫學領域具有重要意義。
– **醫療器材開發與法規認證上市:** 他積極參與醫療器材開發和法規認證,確保患者得到最安全的醫療設備。
– **幹細胞自動化萃取器專利發明:** 他的創新精神在幹細胞自動化萃取領域有著傑出的貢獻。
– **幹細胞應用于抗衰老回春治療:** 他的專業知識將幹細胞技術應用於抗衰老治療,幫助患者重獲青春。
– **慢性傷口修復與毛髮再生醫療:** 他關注慢性傷口治療和毛髮再生,改善患者生活品質。
– **免開刀退化性關節炎軟骨再生:** 他的研究為退化性關節炎患者提供了創新的治療方法。
– **素食營養的實踐與推動:** 他積極宣導素食營養,推動健康生活方式。
鄧守成醫師的醫學旅程是多領域知識的交匯,為患者提供了更多可能性,將醫學與創新完美融合,助力人們追求更健康、更美好的生活。
幹細胞治療服務

臉部軟組織填充
脂肪幹細胞
全台首件運用於軟組織填充進階新療法

慢性傷口與燒燙傷
促進周邊微小血管新生與受損皮膚的再生與修復

退化性關節炎
傳統手術前的免開刀的新選擇,運用脂肪幹細胞用於膝關節注射

疤痕與皺紋改善
纖維母細胞修復陳舊性疤痕,改善的外觀以及膚質
抗衰老療程
- 未來醫療是從細胞分子監控層次來降低潛在的疾病風險
- 身體解毒、新陳代謝、基因和健康弱點的個人化療程
- 食物營養生活形態、內分泌細胞組織的修復等提案
- 精神與外貌維持良好狀態

精準醫學實驗室檢測
- 肝膽腸胃血液生化檢查
- 男女性及抗初老荷爾蒙代謝
- 血脂肪代謝及風險
- 進階過敏原分析
- 情緒、壓力、失眠等檢測評估
- 深度基因檢測、癌症風險評估

細胞療法
- 自體生長因子增益
- 免疫細胞儲存
- 幹細胞儲存
- 身心功能優化

基因檢測
- 失智基因檢測
- 癌症預防基因檢測
- 髮質基因,雀斑風險
- 減肥難易程度,“吃貨”基因
- 減肥反彈風險,“小肚腩”基因
- 抗化妝品損傷過敏能力

功能性醫學療法
- 頻率共振部位平衡
- 高能雷射細胞調養
- 腸道機能調整
- 荷爾蒙平衡治療
- 血液淨化療程
- 螯合排毒療法
恢復青春,從細胞開始
活出健康與美麗的生活
幹細胞培養與製造
我們醫學中心擁有自己的細胞萃取與培養工廠。也有整套幹細胞生產所需的檢測設備,包含細胞計數,高倍蔡司顯微鏡,微生物汙染檢測,以及細胞表面抗原檢測,核苷酸測定等等儀器,除了大型密閉式GMP等級的手套箱外,還有數台微生物操作台,可提供臨床試驗幹細胞生物技術操作,以及濃縮萃取使用。也歡迎與我們洽詢幹細胞代工生產,以及人體試驗劃或特管法計劃書之撰寫與合作送件。
體質調養與高效能艾灸
溫經艾灸
⮊經絡上選取相應穴位
⮊溫通經脈
⮊驅逐寒濕
經絡埋線
⮊增加循環
⮊利水消腫
⮊分解脂肪
- 仙朵拉公主白嫩嫩治療
- 莫克的吶喊抗憂鬱治療
- 鳥頭排愛你好壯陽治療
- 彩色人生肝臟代謝治療
- 菩薩吃素延年益壽治療